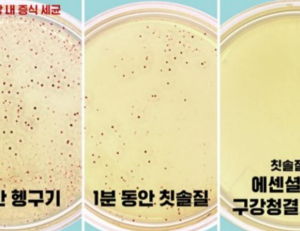
기사이미지
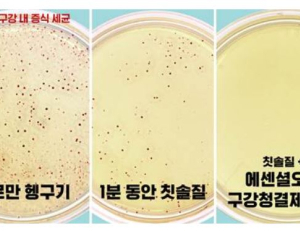
기사이미지

-

- 100세 시대, 연령대별 건강한 구강관리 치아 질환 예방법
- 우리나라는 기대수명의 급속한 증가로 이미 고령사회를 맞이했으며, 수년 내로 초고령사회에 진입할 것으로 예측된다. 많은 이들이 단순히 ‘오래 사는 것’...
- 2021-12-22
-
- 충치 치료 시 치아의 재생 능력 높일 수 있는 재료 개발
- 최성환 연세대 치과대학 교정과학교실 교수, 권재성 치과생체재료공학교실 교수, 홍진기 연세대 공과대학 화공생명공학과 교수 연구팀이 충치 치료 시 치아의 재생 능력을 높일 수 있는 재료를 개발했...
- 2021-12-10
-

- 돌출입 치아교정, 비발치 교정법 유효성 입증
- 국윤아 가톨릭대 서울성모병원 치과병원 교수(교신저자), 치과교정의 파와즈 알 파와즈(Fawaz Alfawaz, 제1저자, 본원 레지던트 수료) 연구팀이 심한 수평피개를 ...
- 2021-12-07
-

- 찬물 마실 때 이가 시큰 시큰! 치아에 문제 있다는 경고
- 바람이 점점 차가워지고 있다. 찬물로 양치질을 하거나, 혹은 따뜻한 차 한 모금 마셨다가 갑자기 칼바람 맞은 것처럼 이가 시려서 놀란 적이 있다면, 겨울은 ...
- 2021-12-06
-

- 마스크 속 입냄새, 유독 심하게 느껴지는 까닭은
- 코로나19 바이러스 팬데믹으로 마스크를 착용하는 시간이 길어지면서 본인 입냄새를 자각하고, 불쾌함을 느끼는 경우가 많아졌다. 양치질을 꼼꼼히 하는데도 ...
- 2021-11-17
-

- 건강한 치아 유지 위한 건보혜택 연령따라 받으세요
- 건강보험제도는 국민들이 평소에 보험료를 내고 보험자인 국민건강보험공단이 관리·운영하다가 필요시 보험급여를 제공하는 사회보장제도이다. 대부분은 ...
- 2021-11-03
-

- 자다가 “컥!”수면무호흡, 양악 전진술로 치료 가능
- 잠을 잘 때 코를 심하게 골거나, 코골이 중 “컥!” 소리를 내며 호흡을 멈추는 사람이 있다. 이러한 코골이나 수면무호흡증은 주변 사람들의 수면을 방해할 ...
- 2021-10-13
-
- 올바른 구강관리는 코로나 시대 건강지키는 초석
- 코로나19 사태 이후로 신체 건강에 대한 관심은 전반적으로 높아진 반면, 구강 건강에 대해서는 여전히 관심과 노력이 부족하다는 지적이 나오고 있다. 보통 감기가 가장 빈도가 높은 질환일 것으로 생각...
- 2021-10-08
-
- 턱교정수술 후 나이들면 잇몸 등 부작용 없을까
- 턱교정수술은 위·아래턱의 위치 관계가 맞지 않아 발생하는 골격성 부정교합을 바로잡는 수술로써, 위·아래턱의 성장이 완료된 이후에 시행해야 한다. 성장 완료 시기는 성별이나 개인별로 차이가 있을 ...
- 2021-09-28
-

- 교정기 착용 중 칫솔질만 하면 치주질환 46% 증가 위험
- 코로나19 장기화로 마스크 착용이 일상화되어 치아교정을 하는 사람들이 증가하고 있다. 마스크를 착용하면 자연스럽게 입이 가려지기 때문에 그동안 교정 장...
- 2021-09-15
-

- 잇몸질환 환자 위암, 인후암 발생률 높다
- 입안 세균이 치아와 잇몸만 상하게 하는 것이 아니다. 대개 잇몸 부위 염증(치은염)에서부터 시작하는 치주 질환은 잇몸이 검붉게 변하고 피가 나는 것이 특징...
- 2021-09-13
-

- 어금니 없어도 된다? … 노년층 임플란트 오해와 진실
- 노년층 65세 이상 연령층에 가장 빈번하게 나타나는 구강 기능장애는 대부분 치아 결손에 관련된 것이다. 치아 상실 시 가장 먼저 고려하게 되는 것이 바로 임...
- 2021-09-09
-
- 연세대 치대 연구 주도 새 충치 진단법 건강보험 적용
- 김백일 연세대 치과대학 예방치과학교실 교수팀이 연구를 주도해 온 치아우식증(충치) 진단 신의료기술이 건강보험 급여 항목으로 인정받았다. 연세대 치과대학과 치과대학병원이 기초 및 임상 연구, 신...
- 2021-08-24
-
- 다이어트, 입 냄새 유발… 효과적인 제거법은?
- 최근 입 냄새가 심해진 것 같다면 마스크 때문일까, 아니면 과도한 다이어트 때문일까. 심한 운동, 긴 공복시간, 식사량 감소 등은 입 냄새를 유발할 수 있다. ...
- 2021-08-19
-

- 누렇고 얼룩럴룩 어린이 '치아 저광화' 조기발견 중요
- 아이들은 만 6세쯤 이갈이를 시작하게 된다. 유치가 빠지고 새로 올라오는 영구치들은 보통 유치보다 두껍고 구성성분 자체가 달라서 더 누렇게 보인다. 특히 ...
- 2021-08-13
-
- 찬음식 먹는 여름철, 구강관리 양치만으론 안된다
- 여름철엔 구강 건강에 특히 유의해야 한다. 찬 음식은 구강 건강을 저해할 수 있어, 과도하게 섭취하지 않도록 주의가 필요하다. 특히, 아이스크림이나 음료수...
- 2021-08-13
-
- 고약한 마스크속 입냄새 대부분 구강내 문제
- 코로나로 마스크 착용이 일상화되면서 입냄새에 대한 고민도 크게 늘었다. 구취는 성인 인구의 절반 정도가 겪는다고 보고될 만큼 흔하다. 생명에 위협이 되거나 통증을 유발하지 않아서 쉽게 생각할 수 ...
- 2021-08-06
-

- 마스크 쓰는 지금이 치아교정 적기이다
- 치아교정은 시간도 오래 걸리고 외관상 교정 장치가 다른 사람들에게 보이는게 부담이 되어 치료를 미루고 꺼리는 경우가 많다. 하지만 마스크 없이는 생활이...
- 2021-07-29
- 많이 본 뉴스
-
-
1
한국로슈 발작성 야간 혈색소뇨증(PNH) 희귀질환 신약 ‘피아스카이주’(크로발리맙)’ 국내 허가
-
2
JW중외제약, 리바로 국내 출시 20주년 기념 인포그래픽 공개 … 올 3분기 누적 매출 1413억원, 내년에 ‘리바로페노…
-
3
한국MSD ‘키트루다’, 내년 1월부터 미충족 수요 높았던 소외 암종에 보험급여 확대
-
4
크레스콤, 골연령 분석 AI ‘MediAI-BA’ 美 FDA 510K 허가 획득 … 소아 손가락뼈 X-레이를 5초만에 분석
-
5
사노피, 주1회 투여 지속형 혈우병A 치료제 ‘알투비오주’ 국내 허가
-
6
대한병원의학회 창립, 초대 회장에 신동호 연세대 교수 선출 … 이사장엔 한승준 서울대병원 내과 교수
-
7
SK케미칼–넥스트젠바이오사이언스, AI 기반 오픈이노베이션 신약개발 … 후보물질 도출부터 비임상까지 공동 진…
-
8
한림대 동탄성심병원, 약물 없이 초음파로 알츠하이머 원인 물질 65% 제거
-
9
경북대병원, 비만 환경에서 간암 면역항암치료 저항성 유발 기전 규명
-
10
가톨릭대, 인간 적혈구 기반 비장 표적 생체모사 나노면역치료 플랫폼 개발